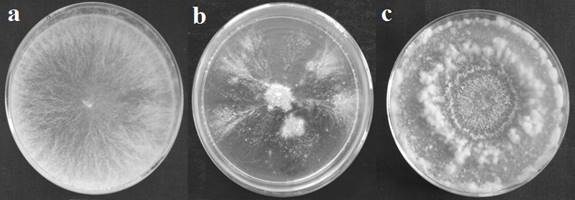

Anita Mukati1, Harish Vyas2 and
Alka Vyas1*
1 School of Studies in
Microbiology, Vikram University, Ujjain (M.P.) 456
010, India
2 Government Kalidas Girls College, Ujjain (M.P.) 456010, India
*Corresponding author, Email: alka_vyas_in@yahoo.com
Fungal Genetics Reports 61:1-8
(pdf)
Neurospora is a tropical fungus which is
found abundantly growing on burnt sugarcane, discarded corn cobs and other
burnt vegetation. It is being used as a model organism for understanding growth
and branching in fungi. We have isolated and characterized a naturally
occurring branching mutant of
Neurospora intermedia which may be useful for understanding growth and branching in fungi.
Introduction
Neurospora has been studied
extensively to understand various phenomenon of fungal growth and
morphogenesis. Fungal morphogenesis is a complex process which includes
important aspects like polarized extension of the hyphal tip and hyphal
branching. Observations at the tip have shown that growth vesicles arrive at
the tip from proximal locations, and then seem to be distributed into the tip
dome by the spitzenkorper. No specific mechanism has
been defined for branching. Several theories have been proposed for branching
that can be broadly divided into two groups. One group supports the mechanism
involving origin of branch initiation factors at the hyphal tips (Bachewich and Heath, 1997; Kaminskyj
and Heath, 1996; Riquelme and Bartnicki-Garcia, 2004;
Watters and Griffiths, 2001). Other group suggests that the signals for branch
initiation originate from within the colony or mycelial body (Prosser and Trinci, 1979; Trinci, 1974;
Watters, 2006). Watters et al., (2000) proposed that the branching
initiation is not completely controlled by the tip but, to some extent by
factors occurring at previous branch point. Trinci
(1974) proposed that mutation or factor which reduces the maximum rate of tip
extension without disturbing the rate of vesicle production would results in an
increase in the frequency of branch initiation without reducing the overall
rate of hypha formation. Recently it has been found that the fungal growth rate
show relationship with the frequency of hyphal branching (Watters et al.,
2008, 2011). In this paper we describe a naturally occurring mutant of N. intermedia which shows defect in
branching and the inheritance of this defect in the progeny.
Material
and Methods
Fungal
strains used and growth conditions
Tester strains used in the study N. crassa
[74-OR23-IVA (FGSC 2489 mat A), fl (FGSC 4317 mat A), fl
(FGSC 4347 mat a)], N.
intermedia (FGSC 1766 mat A
and FGSC 1767 mat a), N. sitophila (FGSC 2216 mat A) and N. discreta (FGSC 3228 mat A) were obtained from Fungal Genetic
Stock Centre, Kansas City, USA. N. intermedia
strain (RM126-3A) was obtained from Professor R. Maheshwari.
Neurospora cultures were grown on Vogel’s minimal media and incubated at 34±2
°C and all growth conditions were as described by Davis and de Serres (1970). The extension growth rate was determined by
measuring the growth of the cultures in the race tubes (Ryan, 1950).
Isolation and identification of Neurospora
A naturally occurring mutant of Neurospora was isolated from
visible colony growing on corn cob at Sanver in
Madhya Pradesh, India, following the method of Perkins and Turner (1988). Its mating type was determined by making spot
crosses with fluffy tester strains by using the method of Perkins et al., (1989). The species was determined as described by Perkins and Turner
(1988) by observing fertility in crosses with tester strains.
Morphological
studies
For studying the morphology, cultures were grown on Petri
dishes containing Vogel’s minimal media and incubated at 34±2 °C. The colony
characteristics were recorded and details of hyphal growth were observed under
microscope (40X, 100X and 400X magnification). The microscopic observations
were taken after 18 - 20 h of growth. The culture was photographed at different
magnifications and the photographs were used to determine branch angle,
branching frequency, branching interval and distance between tip and first
branch.
Determination of conidiation
banding pattern
The conidiation pattern in response
to light/dark cycles was studied in S9-5 by growing the culture in race tube
containing Vogel’s minimal agar medium and incubating at 34±2 oC under 12 h light/12 h dark (LD) condition.
The conidiation pattern under different conditions of
light and temperature was studied in culture AM68-8 (progeny of S9-5) using the
modified method of Sargent and Kaltenborn (1972). The
culture was grown in race tubes and incubated at 25±2 oC,
30±2 oC and 34±2 oC
under 12 h light/12 h dark (LD), constant light (LL) and constant dark (DD)
conditions. The light was provided by cool white fluorescent light (Surya, 8
Watt). The position of the growth front was marked at 24 h intervals. The
period length of the conidiation bands was determined
following the modified method of Feldman and Hoyle (1973). The time of each
band was determined at the end of the experiment by measuring the position of
the center of each band. The period lengths between successive bands were
averaged to determine the period length of the culture.
Inheritance
of the morphological defects
To study the inheritance of morphological defects the
mutant was crossed with tester strains of N. intermedia (FGSC 1767 mat a or RM126-3A). Twenty viable
progeny from each cross were screened for morphological defects to determine if
they inherited the parental defect or not. To determine cytoplasmic (plasmid/
mitochondrial) or nuclear basis of inheritance reciprocal crosses were made.
Results and
Discussion
Isolation,
identification and characterization of S9-5
A Neurospora culture namely S9-5 was isolated from the visible conidial
sample collected from Sanver (Madhya
Pradesh). The culture was purified and
it was identified as N. intermedia and its mating type was found to be mat
‘a’. The culture has yellow coloured conidia and
thus it is the yellow ecotype of N. intermidia which is predominantly present in Ujjain and
areas in its vicinity (Mukati et al., 2012). The morphology of the culture (S9-5) was studied
under the microscope and the results show that it has multiple defects
in growth and branching. S9-5 is a slow growing culture and the extension
growth rate is shown in Figure 1. As seen from the graph the culture shows
erratic growth. Initially the culture
grows with an extension growth rate of approximately 2 mm/h. Thus, there is about
two fold reduction in growth rate as compared to wild type N. intermedia
(RM126-3A) which grows with the
growth rate of 4.1 mm/h (Figure 1). During further incubation growth
rate of S9-5 is further reduced and after few days only submerged growth takes
place with highly reduced growth rate and then growth stops completely. The
growth is completely stopped for 2 days after which the growth resumes again
(Figure 1). Thus S9-5 is a stop start mutant.

Figure 1: Extension
growth rates of wild-type N. intermedia (RM126-3A),
S9-5 and AM68-8.
When grown on a Petri dish, initially the culture forms a thick circular mycelial
mat and then growth stops (Figure 2b). After some-time the growth resumes from
a few points in the circular colony. At these points hyphae extend and grow in
a feather-like pattern (Figure 2b). Surface growth takes place for few hours
then short aerial hyphae are formed.
Figure 2: Morphology of wild-type and
morphological mutants growing on Vogel’s minimal agar media at 34±2 °C
temperature. (a) Wild-type (N. intermedia,
RM126-3A), (b) S9-5 and (c) AM68-8.
When observed under microscope the
culture shows defects in branching (Figure 3). During initial growth of
culture branching occurs at almost right angles (Figure 3d). The lateral
branches are short and show infrequent branching or remain unbranched. In later
phase of growth branching frequency increases (Figure 3e and 3f). New branches
arise from sites that are very close to the hyphal tips (Figure 3i) and at many
places dichotomous branching (Figure 3f and 3g) is also seen. At some points
the tip becomes swollen (Figure 3h). The hyphae do not grow straight but take
an undulated pattern (Figure3j).
S9-5 showed conidiation bands when
it was grown in race tube at 34±2 oC under
12 h light/12 h dark (LD) conditions. The period length of the bands was found
to be 25.6±0.2 h. The wild-type control
(RM126-3A) did not show conidiation bands under these
conditions (Figure 4).

Figure 3:
Hyphal morphologies of wild-type strain of Neurospora
(a-c), S9-5 (d-j) and AM68-8 (k-q) at 34±2 °C. Fungi were grown on Vogel’s
minimal agar medium for 24 h and images were taken at 40X, 100X and 400X
magnification.

Figure 4: Conidiation bands in cultures incubated at
34±2 °C under 12 h light/ 12 h dark (LD) conditions.
Inheritance
of morphological defects
S9-5 was crossed with tester strain of N. intermedia
namely RM126-3A to see the inheritance of defects in progeny. Reciprocal
crosses were set up in order to see whether the defects in S9-5 were due to
mutations in nuclear gene or due to presence of some cytoplasmic factor like
plasmid. Random ascospore analysis (Davis, 2000) was
done after one month. Twenty viable progeny from each cross were studied. Each
progeny was examined for colonial and hyphal characters. The results show that conidiation banding pattern and frequent dichotomous
branching are inherited in the progeny in both the crosses. The inheritance of
both characters is almost same in reciprocal crosses so it can be inferred that
these characters may not be controlled by cytoplasmic factor/gene. Conidiation banding
pattern and dichotomous branching are not inherited together so they may be
controlled by different nuclear genes. From these crosses single progeny namely
AM68-8 was chosen for further study.
Characteristics of AM68-8
The extension growth rate of AM68-8 was measured and results
are shown in Figure 1. It can be seen that the growth rate is approximately 1.6
mm/h thus there is about 2.5 fold reduction in growth as compared to the wild
type (RM126-3A) parent. However its growth rate is not erratic as it was in the
parent S9-5.
When grown on solid Vogel's minimal media in Petri dish, then
initially for about 18 – 20 h only surface growth occurs and few aerial hyphae
are formed. During further incubation vigorous aerial hyphae formation takes
place which lasts for few hours then again surface growth takes place. When
Petri dish was observed from above the aerial hyphae gives the appearance of
ring (Figure 2c).
The culture was examined under the microscope to study the
branching pattern. It was observed that the culture has clear dichotomous
branching at the tip (Figure 3k and 3l). However, when the initial emergence of
new branch was examined, three types of patterns of branch initiation were
seen. (i) A
new branch arises below the tip but extremely near to the tip (Figure 3n and
3o). Both tip and new branch grows almost at equal rate and it appears that
branching is dichotomous (Figure 3p). (ii) Tip bifurcates into two branches and
branching is dichotomous in true sense (Figure 3m and 3q). (iii) Multiple
branches arise from tip (Figure 3l). But the overall culture appears to be
dichotomously branched (Figure 3k and 3l). All the three types of branching are
equally prevalent in the culture. AM68-8 is also female sterile i.e. it is
infertile when used as a female parent in a genetic cross.
AM68-8 was grown in race tubes and incubated at 25±2 oC, 30±2 oC
and 34±2 oC
under 12 h light/12 h dark (LD), constant dark (DD) and constant light (LL)
conditions and the conidiation banding pattern was
recorded. Wild-type RM126-3A was used as control. The results are shown in
Table 1 and Figure 5. AM68-8 shows conidiation bands
with period length of 25.1±0.2 h and 25.3±0.2 h at 30±2 oC
and 34±2 oC
respectively under all three light conditions. The period length under all
three conditions did not change much. Interestingly, AM68-8 did not show any conidiation band at 25±2oC under all the
conditions of light. In the control (RM126-3A) conidiation
bands with period length of 21.3±0.2 h
were seen under constant dark condition at 25±2 oC,
30±2 oC and 34±2 oC,
but conidiation bands were absent under 12 h light/12
h dark (LD) and constant light (LL) conditions at all the temperatures.
Table 1. Occurrence of conidiation
bands in AM68-8 and RM126-3A at different
temperature and light conditions.
|
S. No. |
Culture No. |
Temperature |
||||||||
|
25±2oC |
30±2oC |
34±2oC |
||||||||
|
LD |
DD |
LL |
LD |
DD |
LL |
LD |
DD |
LL |
||
|
1 |
AM68-8 |
- |
- |
- |
+ |
+ |
+ |
+ |
+ |
+ |
|
2 |
RM126-3A |
- |
+ |
- |
- |
+ |
- |
- |
+ |
- |
LD = 12 h light/ 12 h dark condition, DD = constant dark condition, LL =
constant light condition, + = indicates
presence of conidiation bands, - = indicates absence
of conidiation bands.

Figure 5: Conidiation bands in race tubes under constant
dark conditions (DD). (a) AM68-8 at 25±2 oC,
(b) AM68-8 at 30±2 oC, (c) AM68-8 at 34±2 oC and (d) RM126-3A at 25±2 oC.
Inheritance
of morphological defects
AM68-8 was crossed with tester
strain of N. intermedia (FGSC # 1767) to see the inheritance of defects.
Reciprocal crosses were not possible as the mutant culture is female sterile.
Random ascospore analysis (Davis, 2000) was done
after one month. Twenty viable progeny were studied. Each progeny was examined
for colonial and hyphal characters. It was seen that 9 progeny had hyphal
morphology similar to the parent AM68-8 (dichotomous branching pattern) whereas
11 cultures had wild-type hyphal morphologies. This indicates that about 50% of
the progeny inherited the dichotomous branching pattern and this character may
be controlled by a single gene. All the progeny were examined for the presence
of conidiation bands under 12 h light/ 12 h dark
conditions at 34±2 oC. The results show that 8 progenies had
distinct conidiation bands whereas 12 progeny did not
show conidiation bands. This also indicates that
about 50% of the progeny inherited the conidiation
banding pattern. The further analysis showed that 7 progeny inherited both
dichotomous branching and conidiation banding pattern
and 2 progeny had dichotomous branching but no conidiation
bands while 1 progeny had conidiation banding pattern
and wild-type hyphal morphology. These results indicate that most of the
progenies inherit both the characters together i.e., dichotomous branching
pattern and conidiation banding pattern but few
progeny inherit only one character i.e., either dichotomous branching or conidiation banding pattern. Thus both the characters are
not always inherited together. These results suggest that these two characters
may be controlled by two different genes which may be present very close to
each other.
Effect of
temperature on growth and branching
The culture was grown at 25±2 oC
and 34±2 oC temperatures to determine if
there is any difference in growth rate and morphology with change in
temperature and to understand the phenomenon of branch initiation. The
extension growth rate was determined by growing the cultures in race tubes and
at both the temperatures the growth rate was almost the same (1.7 mm/h at 25±2 oC and 1.6 mm/h at 34±2 oC),
however, as compared to the wild type there was about 2.5 fold reduction in
growth rate at both the temperatures. This shows that there is no significant
effect of temperature on growth rate of this mutant. The culture was grown in
Petri dish at both the temperatures (25±2 oC
and 34±2 oC) for 18 h and the difference
in branch angle, branching frequency and branching interval were recorded at
this stage of growth. The distance between tip and new branch point was 235 µm
at 25±2 oC and 130µm at 34±2 oC. It
was observed that at 25±2 oC branch
interval was 194 µm which was reduced to 166 µm at 34±2 oC.
The branch angle was 44o and 53o at 25±2 oC and 34±2 oC
respectively. The frequency of branching was 0.553/100µm and 0.623/100µm at
25±2 oC and 34±2 oC
respectively. Thus the branching frequency and branching angle are higher at
34±2 oC while distance between tip and new
branch point and branching interval are higher at 25±2 oC,
while the growth rate remains almost the same at both the temperatures. As a
result at 34±2 oC temperature the culture
appears hyperbranched and shows predominantly
dichotomous branching, whereas, at 25±2 oC
the culture shows more spreading growth. These results are consistent with the
results of Watters and Griffith (2001), who grew various colonial mutants at
different temperatures and found that at reduced temperature the branching
interval, is increased. Our mutant shows differences in branching frequency,
branch angle, branch interval and distance between tip and new branch point
with change in temperature without showing much change in growth rate. It is
proposed that this could be because at higher temperature the metabolic growth
rate is high due to which large numbers of secretory vesicles reach the tip but
due to some defect (mutation) these vesicles are not incorporated at the tip
and are utilized for lateral branch formation. As a result branch frequency
increases at high temperature i.e. 34±2 oC. At lower temperature,
there may be reduction in metabolic (synthetic) activities due to which fewer
secretory vesicles reach the tip which are utilized for tip extension leaving
fewer vesicles for branch initiation. As a result the branch interval and the
distance between the tip and new branch point increased at 25±2 oC
whereas branching frequency decreased. It is still not clear why the angle of
branching has changed. However, it was reported by Simonin
et al., (2012) that during initial
phase of growth (when colony diameter was 2.5 mm) the hyphae display a
branching angle of ~90o whereas the mature hyphae (when colony
diameter was 5 mm) display branching angles of ~50o i.e. hyphal architecture changes with colony
age. Thus change in branch angle may be related to change in physiology of the
hyphae. This mutant may be useful for future research.
Acknowledgements
We thank
the Fungal Genetic Stock Center (FGSC; Kansas State University) for providing
Neurospora tester strains and waiving the charges. We acknowledge University
Grants Commission, New Delhi (India) Project No. [F.No.36-328/2008(SR)] and MPCST Bhopal (India) Project No.
3586/CST/R&D/Bio.Proj.S/2012 for financial
support. We express our gratitude to
Professor Ramesh Maheshwari (Formerly at Department
of Biochemistry, Indian Institute of Science, Bangalore,
India) for constant inspiration and support.
References
Bachewich,
C.L., and Heath, I.B. 1997. Differential cytoplasm-plasmamembrane-cell
wall adhesion patterns and their relationship to hyphal tip growth and
organelle motility. Protoplasma 200:11-86.
Davis, R.H. 2000. Neurospora-
Contributions of a model organism. Oxford University Press, New York.
Davis,
R.H., and de Serres, F. J. 1970. Genetic and
microbiological research techniques for Neurospora. Meth.
Enzymol. 17:79-143.
Feldman, J. F., and Hoyle,
M. N. 1973. Isolation of circadian clock mutants of Neurospora crassa. Genetics 75:606–613.
Kaminskyj, S.G.W., and Heath, I.B.
1996. Studies on Saprolegnia ferax suggest
the general importance of the cytoplasm in determining hvphal
morphology. Mycologia 88:20-37.
Mukati, A., Vyas, A., and Vyas, H. 2012. A study of natural
population of Neurospora. J. Environ. Res. Develop. 7:923-935.
Perkins, D. D., and Turner,
B.C. 1988. Neurospora from
natural populations: Towards the population biology of a haploid eukaryote. Exp. Mycol. 12(1):91-131.
Perkins, D. D., Turner, Β. C., Pollard, V. C.,
and Fairfield, A. 1989. Neurospora strains incorporating fluffy and
their use as testers. Fungal Genet. Newsl. 36(1):64-66.
Prosser, J.I., and Trinci, A.P.J. 1979. A model for hyphal growth and
branching. J. Gen. Microbiol. 111:153-164.
Riquelme, M., and Bartnicki-Garcia, S. 2004. Key differences between lateral
and apical branching in hyphae of Neurospora
crassa. Fungal Genet. Biol. 41:842-851.
Ryan, F.J. 1950. Selected
methods Neurospora genetics. Methods
Med. Res. 3:51-57.
Sargent, M.L., and Kaltenborn, S.H. 1972. Effects of medium composition and
carbon dioxide on circadian conidiation in Neurospora. Plant Physiol. 50:171-175.
Simonin, A., Palma-Guerrero, J., Fricker, M., and Glass, N.L. 2012. Physiological
significance of network organization in fungi. Eukaryot.
Cell 11:1345-1352.
Trinci, A.P.J. 1974. A study of
the kinetics of hyphal extension and branch initiation of fungal mycelia. J.
Gen. Microbiol. 81:225-236.
Watters,
M. K. 2006.
Control of branch Initiation in Neurospora.
Proc. Indiana Acad. Sci. 115(1):7-12.
Watters, M.K., Boersma,
M., Johnson, M., Reyes, C., Westrick, E., and Lindamood, E. 2011. A screen for Neurospora knockout mutants displaying growth rate dependent branch
density. Fungal Biol. 115: 296-301.
Watters, M.K., and
Griffiths, A.J.F. 2001. Tests of a cellular model for constant branch
distribution in the filamentous fungus Neurospora
crassa. Appl. and Environ. Microbiol. 67:1788-1792.
Watters, M. K., Lindamood,
E.R., Muenich, M., and Vetor,
R. 2008. Strain-Dependent Relationship between Growth Rate and Hyphal Branching
in Neurospora crassa. Proc. Indiana Acad. Sci. 117(1):1-6.
Watters, M.K., Virag, A., Haynes, J., and Griffiths, A.J.F. 2000. Branch
initiation in Neurospora is
influenced by events at the previous branch. Mycol. Res. 104:805-809.